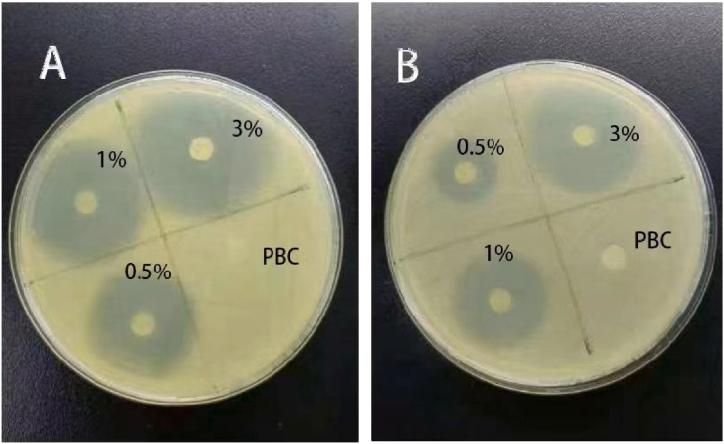

抗菌聚碳酸1,4 - 丁二醇酯:作为鼓膜修复材料的制备、表征及潜在应用
Antimicrobial poly (1,4-butylene carbonate): Preparation, characterization, and potential applications as a material for tympanic membrane repair.
作者信息
Lv Yuan, Wu Linrong, Yan Jiangyu, Shen Zhisen, Zhang Junjun, Zhang Xiaoqin, Li Tian
机构信息
The Department of Otolaryngology, Head and Neck Surgery, Ningbo Medical Center Lihuili Hospital, Ningbo, Zhejiang, China.
Department of Trauma Surgery, Yinzhou No.2 Hospital, Ningbo, Zhejiang, China.
出版信息
Heliyon. 2024 May 27;10(11):e31789. doi: 10.1016/j.heliyon.2024.e31789. eCollection 2024 Jun 15.
Perforation of the tympanic membrane (TM) is a common condition that often requires a scaffold as a support for surgery. However, because of the external environment of the auditory canal, the scaffold could become bacterially infected and prevent the TM from healing. As a result, the perfect scaffold should have both antibacterial and biomimetic qualities. In this study, the biodegradable biomaterial poly(1,4-butylene carbonate) (PBC) films containing levofloxacin (LEV) was successfully prepared for the first time. The results showed that the hydrophilicity of the LEV/PBC film was improved after the addition of LEV, and the tensile strength was also complied with the requirements of the standard. The created antibacterial film demonstrated excellent antibacterial properties. In vitro hemolysis experiments revealed no risk of hemolysis for the new material, and the cytotoxicity study further confirmed its non-cytotoxic nature. Overall, LEV was a good component of PBC/LEV film, which is expected to be used for TM repair in the future.
鼓膜穿孔是一种常见病症,通常需要支架来辅助手术。然而,由于耳道的外部环境,支架可能会受到细菌感染,从而阻碍鼓膜愈合。因此,理想的支架应兼具抗菌和仿生特性。在本研究中,首次成功制备了含左氧氟沙星(LEV)的可生物降解生物材料聚(1,4-碳酸丁二酯)(PBC)薄膜。结果表明,添加LEV后,LEV/PBC薄膜的亲水性得到改善,拉伸强度也符合标准要求。所制备的抗菌薄膜表现出优异的抗菌性能。体外溶血实验表明该新材料无溶血风险,细胞毒性研究进一步证实了其无细胞毒性的特性。总体而言,LEV是PBC/LEV薄膜的良好组成成分,有望在未来用于鼓膜修复。